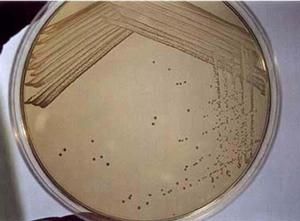
單菌落

基本內容
單菌落就是單個細菌形成的菌落,是用於計算細菌數量的一種方法。而且單菌落上的細菌性質是一樣的,DNA、所處細胞期都一樣,便於科學研究,一個單菌落一般就是一個圓點。
單菌落是指來源於單一孢子或營養細胞或一群相同的細胞在固體培養基表面或內部形成的肉眼可見的集合體。
單菌落:單菌落單菌落就是單個細菌形成的菌落,是用於計算細菌數量的一種方法。而且單菌落上的細菌性質是一樣的,DNA、所處細胞期都一樣,便於科學研究,一個單菌落一般就是一個圓點。
單菌落就是單個細菌形成的菌落,是用於計算細菌數量的一種方法。而且單菌落上的細菌性質是一樣的,DNA、所處細胞期都一樣,便於科學研究,一個單菌落一般就是一個圓點。
單菌落是指來源於單一孢子或營養細胞或一群相同的細胞在固體培養基表面或內部形成的肉眼可見的集合體。
